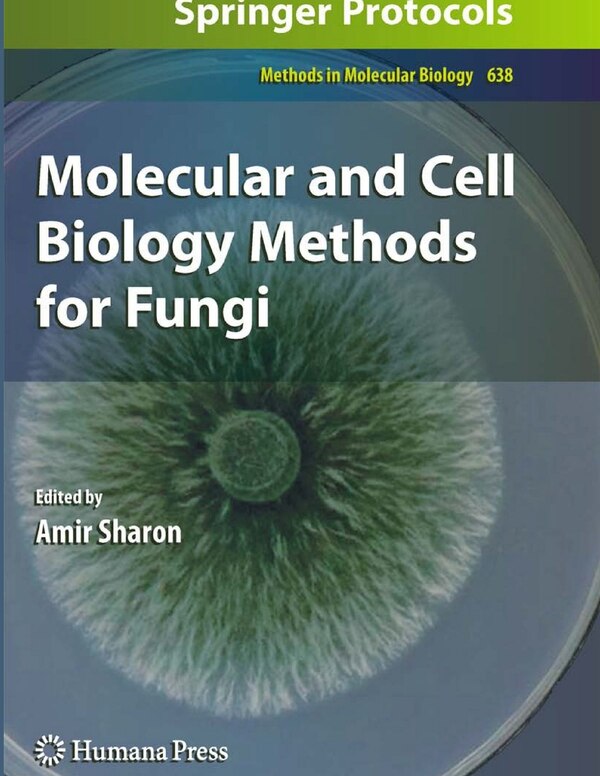

Amir Sharon
Molecular and Cell Biology Methods for Fungi by Amir Sharon, Paperback | Indigo Chapters
From Indigo
Current price: $80.95
One moment, we’re checking the availability for this product
Amir Sharon
Molecular and Cell Biology Methods for Fungi by Amir Sharon, Paperback | Indigo Chapters
From Indigo
Current price: $80.95
One moment, we’re checking the availability for this product
Size: 0.66 x 11 x 1.62
* Product availability, descriptions and images provided by Indigo. Contact Indigo to confirm product details. Prices shown are only available through StyList. Prices may be higher or lower in store or on Indigo's website. Indigo is not required to honour the StyList price if you choose to shop directly with Indigo. Product availability is not guaranteed. Please see Terms of Use.










